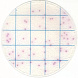

Тест-пластина KangarooSci для подсчета E. сoli и колиформных бактерий основана на стандартном методе ISO/AOAC, в котором используется обезвоженная культуральная среда на подложке для культивирования бактерий.
Подходит для микробиологического анализа сырья, полуфабрикатов, готовых продуктов и объектов окружающей среды.
После культивирования подсчет колоний проводится ручным или автоматизированным способом.